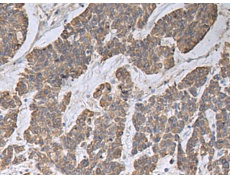
一抗

中文名稱:兔抗CCNF多克隆抗體
別 名: cyclin F; FBX1; FBXO1
抗 原: CCNF
儲 存: 冷凍(-20℃)
宿 主: Rabbit
相關(guān)類別: 一抗
反應(yīng)種屬: Human
標(biāo) 記 物: Unconjugate
克隆類型: rabbit polyclonal
技術(shù)規(guī)格
|
Background: |
This gene encodes a member of the cyclin family. Cyclins are important regulators of cell cycle transitions through their ability to bind and activate cyclin-dependent protein kinases. This member also belongs to the F-box protein family which is characterized by an approximately 40 amino acid motif, the F-box. The F-box proteins constitute one of the four subunits of the ubiquitin protein ligase complex called SCFs (SKP1-cullin-F-box), which function in phosphorylation-dependent ubiquitination. The F-box proteins are divided into 3 classes: Fbws containing WD-40 domains, Fbls containing leucine-rich repeats, and Fbxs containing either different protein-protein interaction modules or no recognizable motifs. The protein encoded by this gene belongs to the Fbxs class and it was one of the first proteins in which the F-box motif was identified. |
|
Applications: |
ELISA, WB, IHC |
|
Name of antibody: |
CCNF |
|
Immunogen: |
Synthetic peptide of human CCNF |
|
Full name: |
cyclin F |
|
Synonyms: |
FBX1; FBXO1 |
|
SwissProt: |
P41002 |
|
ELISA Recommended dilution: |
5000-10000 |
|
IHC positive control: |
Human colorectal cancer |
|
IHC Recommend dilution: |
50-100 |
|
WB Predicted band size: |
88 kDa |
|
WB Positive control: |
293T cell lysate |
|
WB Recommended dilution: |
500-2000 |


 購物車
購物車 幫助
幫助
 021-54845833/15800441009
021-54845833/15800441009